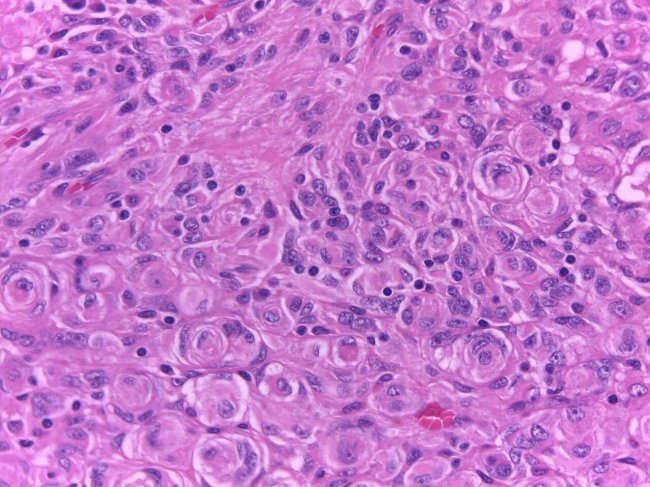

Unidade de Tumores Cerebrais
Hospital CUF Descobertas - Lisboa
A Unidade de Tumores Cerebrais dedica-se ao diagnóstico e tratamento de doentes com tumores do sistema nervoso central. Para isso conta com uma equipa experiente e diferenciada em Neuro-Oncologia, que atua de acordo com os mais elevados padrões de qualidade, alinhados com os centros de referência internacionais.
Organização clínica
Na CUF Oncologia, a Unidade de Tumores Cerebrais está organizada em dois núcleos principais, com coordenação regional das Unidades de saúde CUF, no sul e no norte do país. Esta organização visa uniformizar procedimentos, promover a partilha de conhecimento e experiência, e otimizar a abordagem a estes tumores, frequentemente raros e complexos.
A unidade conta com equipas multidisciplinares, formadas por médicos especialistas em Neurocirurgia, Neuro-Oncologia, Oncologia Médica, Neurorradiologia Oncológica, Neuropatologia, Radio-Oncologia e Medicina Nuclear. Estes profissionais são apoiados por enfermeiros especializados em Neurorreabilitação e Oncologia e farmacêuticos com foco no tratamento oncológico.
Adicionalmente, a Unidade assegura o acesso a serviços complementares essenciais, incluindo Medicina Física e Reabilitação, Onco-Psicologia, Neuropsicologia, Nutrição, bem como o apoio do Gestor Oncológico e Assistente Social.
Deste modo, o acompanhamento do percurso clínico do doente e dos seus cuidadores é realizado de forma contínua e personalizada.
Coordenação:
Unidade de Tumores Cerebrais a Sul: Daniela Garcez, Neurologista, e Catarina Viegas, Neurocirurgiã
Unidade de Tumores Cerebrais a Norte: Paulo Linhares, Neurocirurgião, e Cláudia Caeiro, Oncologista
O que nos distingue?
+ Tecnologia Avançada
Para além do corpo clínico e organização multidisciplinar, a Unidade de Tumores Cerebrais da CUF distingue-se por ser a única unidade do país com acesso a tecnologia avançada, como a Gamma Knife, aparelho de radioterapia específico para o tratamento de tumores cerebrais com elevada precisão e segurança.
A unidade destaca-se também pela possibilidade de realizar cirurgia acordada (awake surgery), com monitorização intraoperatória contínua, proporcionando maior segurança na remoção de tumores localizados em áreas eloquentes do cérebro.
+ Precisão no diagnóstico:
- Técnicas avançadas de ressonância magnética, incluindo espectroscopia (com pesquisa seletiva de metabolitos consoante o subtipo de tumor), técnicas de difusão (DWI, DTI com tratografia), perfusão (incluindo DSC, DCE e ASL), estudo funcional (fMRI), entre outras técnicas, tratando-se de uma mais valia para o diagnóstico diferencial de tumores cerebrais;
- PET com aminoácidos, uma ferramenta valiosa na caracterização de lesões cerebrais, sobretudo em situações em que a ressonância magnética não permite um diagnóstico conclusivo (distinção entre progressão tumoral e lesões induzidas pela radioterapia, entre outros);
- Estudos de biologia molecular, com acesso a painéis alargados de Next Generation Sequencing (NGS) e análise por array de metilação para o diagnóstico de casos mais complexos, realizados em articulação com laboratório externo especializado e com consultoria dedicada em tumores cerebrais.
Faça o seu pedido de contacto para o podermos acompanhar desde o primeiro momento.
Se preferir pode agendar uma consulta através da nossa linha gratuita.
As especialidades frequentemente envolvidas na orientação dos doentes com tumores do sistema nervoso são:
- Neurorradiologia
- Neurocirurgia
- Neuropatologia
- Neuro-Oncologia
- Oncologia Médica
- Radio-Oncologia
- Neurofisiologia
- Neuropsicologia
- Enfermagem, com especialidade em Neurorreabilitação - ‘Clinical Navigator’
Os meios de diagnóstico inicial são a TC (tomografia computorizada) e a RMN (ressonância magnética) – que mostram o tumor, definindo a sua localização e aspetos de imagem sugestivos de qual o tipo de tumor.
As imagens obtidas servem de base para colocar algumas hipóteses de diagnóstico, conforme a localização do tumor e as características imagiológicas desses exames. Servem também para o planeamento da melhor intervenção cirúrgica.
O diagnóstico definitivo implica, geralmente, a obtenção de uma amostra do tumor para análise anátomo-patológica (diagnóstico do tecido removido por cirurgia ou biópsia) e estudos de biologia molecular (caracterização genética do tumor).
Para que a cirurgia seja realizada da forma mais segura e eficaz possível, permitindo a remoção máxima do tumor sem comprometer a função neurológica, os neurocirurgiões podem recorrer a diversas técnicas, como cirurgia acordada com monitorização intra-operatória, monitorização neurofisiológica, neuronavegação, fluorescência tumoral, ecografia intra-operatória, entre outros.
O plano terapêutico é discutido e decidido em sede multidisciplinar, reunião semanal que reúne médicos de diversas especialidades (Neurocirurgia, Neuro-Oncologia, Neurorradiologia, Neuropatologia, Radio-Oncologia, Medicina Nuclear, Enfermagem - Nurse Navigator, Gestor Oncológico e consultor externo de Biologia Molecular). Esta integração entre diferentes disciplinas permite a definição de estratégias mais personalizadas e, consequentemente, mais eficazes.
O tratamento pode incluir de forma isolada, concomitante ou sequencial: cirurgia, radioterapia, quimioterapia, terapêutica alvo ou ainda a inclusão em ensaios clínicos.
Serviços Clínicos de Apoio
- Bloco Operatório
- Internamento
- Cuidados Intensivos
- Neurorreabilitação
- Hospital de Dia
- Nutrição
- Onco-psicologia
- Equipa de Apoio ao Domicílio
- Cuidados Paliativos
- Assistente Social
- Atendimento Permanente
- Todas as restantes especialidades
Outros serviços:
- Linha de Apoio geral 24 horas
- Linha de Apoio Nurse Navigator
- Linha de Apoio Gestor Oncológico
- Linha de Apoio Hospital de Dia
- Avaliador de sintomas com inteligência artificial - My CUF
Conheça os tipos de tumores cerebrais que existem e o que a rede CUF disponibiliza para o seu diagnóstico e tratamento.
Centros
Os Centros CUF encontram-se organizados de forma multidisciplinar e agregadora, proporcionando um acompanhamento completo com base numa organização assente num percurso clínico de um grupo de doenças, órgãos ou especialidades médicas.
Informações úteis sobre o Hospital: contactos, horários, como chegar.





